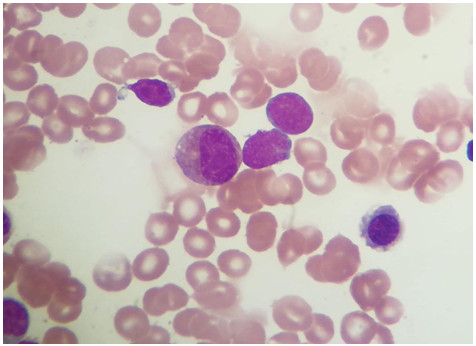

【检验临床面对面】为何骨髓瘤病人的淋巴细胞比例如此高?
作者:吕彩云,浙江省湖州市第一人民医院骨髓室
王某某,女性,60岁,多发性骨髓瘤7年,去年12月份复查骨髓,浆细胞占15%左右,PD方案化疗后缓解,最近来医院复查,简单检查结果如下:血常规结果:

生化类检查:



部分球蛋白及轻链的检查:



凝血类检查:

辅助检查:
CT检查:两肺纹理深,左下肺感染性病变可能,右侧第4前肋陈旧骨折,建议复查。
DR检查:腰椎退变,密度减低,T9、T11、T12、L1、L2椎体变扁,左侧骨盆密度减低。
B超:肝小囊肿,胆囊壁胆固醇结晶。
心脏彩超:左心舒张功能减退。
该患者今年9月来本院常规治疗,虽然外周血象未见异常,但是骨髓检查淋巴细胞比例高达45%左右,细胞形态如下:

骨髓涂片中看到淋巴细胞有小和中等大小,胞浆量少、清亮、无颗粒,染蓝至深蓝色,部分细胞核中度致密,偶见核仁,介乎于幼稚与成熟小淋巴细胞之间,这类细胞约占22%左右,该类细胞POX染色阴性,骨髓检查结果及描述见下面:

骨髓细胞流式结果如下:


流式检查提示该类细胞为Hematogones细胞,流式CD模式表达呈正常分化过程,该病人经过临床观察及血常规检查,没有发现异常。
分析:Hematogones是正常B淋巴细胞的前体细胞,是B祖细胞进一步分化成熟阶段的淋巴细胞,该细胞在骨髓中按成熟程度可分三个期,细胞表面的免疫标记有不同变化,它在骨髓中的出现与B祖淋巴细胞及原始、幼稚及异常淋巴细胞的意义不同,该类细胞依靠形态学难以区分是Hematogones还是幼稚类淋巴细胞,经过适当的细胞流式鉴别可以区分。Hematogones通常在骨髓里发现,在骨髓活检切片里,它通常单个散在或聚集成小簇分布而不会形成大的集落,骨髓涂片是观察hematogones形态的最佳选择。细胞大小与其成熟发育阶段相关,直径10~20µm不等,发育最成熟的hematogones形态上与成熟淋巴细胞相似,细胞染色质聚集或粗糙,明亮有光泽;较幼稚hematogones细胞和ALL中的原始淋巴细胞十分相似,在某些病例中形态上难以区别,由于这类hematogones 核为圆形或椭圆形,可有切迹,染色质模糊、涂抹感,甚至在某些情况下可见清晰的核仁。总之,典型的hematogones胞浆很少,胞浆嗜碱性,缺乏颗粒或空泡。由于从形态上难以将hematogones和肿瘤性的原、幼淋巴细胞区分出来,骨髓中增多的hematogones容易引起相应的误导和误诊,部分化疗后病人、骨髓移植病人的骨髓重建、幼儿ALL化疗后、自身免疫性或先天性血细胞减少、骨髓衰竭、ITP、IDA、病毒感染等疾病也会使hematogones增高。
在平常的工作中,如果骨髓中一、二期的hematogones增多容易误认幼稚淋巴细胞而导致误诊,见下图片。

该类细胞为幼稚淋巴细胞,呈圆形,染色质较致密,核仁隐约,浆量少,透亮蓝色,浆内无颗粒,与一、二期的hematogones相似,图片来自ALL病人。
如果骨髓中三期的hematogones增多容易误认成熟淋巴细胞而导致误诊,见下图片。

该类细胞为成熟淋巴细胞,呈圆形,染色质致密,未见核仁,浆量少,蓝色,部分细胞浆量少,绕核一圈,浆内无颗粒,与三期的hematogones相似,图片来自CLL病人。
总结:随着我们对hematogones的逐渐认识和临床意义的了解,骨髓中此类细胞的出现如果不能很好的识别,对化疗后、骨髓移植后、骨髓衰竭等病人的疗效观察及病情的评估可能会受到一定的影响,因此运用多参数及全面完整的流式分析有利于对该细胞的认识,另外对病人临床病史的详细的了解也是十分必要,随着多参数的流式细胞仪和免疫过氧化物酶染色技术的进展使得准确检测骨髓中的hematogones成为可能。
参考文献:
1.许艳丽,王顺清,杜庆华,等.造血B祖细胞与急性B淋巴细胞白血病细胞的流式细胞术免疫表型分析与鉴别[J].白血病•淋巴瘤,2015,24(5):282-286.
检验视界网微信平台独家首发,转载请注明来源及作者!

